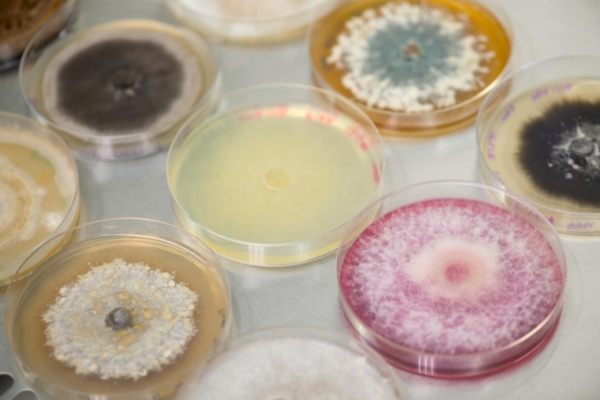

Seed Today
@seedtoday
Seed Today provides news and information for the seed production industry. Join us to receive links to the latest industry news.
ID: 158513105
http://www.seedtoday.com 22-06-2010 22:31:12
2,2K Tweet
2,2K Followers
502 Following


.Stine Seed Company announced the launch of its lineup of soybean blends. The company says these products combine elite genetics with advanced trait packages to deliver unmatched yield stability, disease tolerance, and adaptability across a range of environments: shorturl.at/9h7jt


At the World Economic Forum, Syngenta Group CEO Jeff Rowe presented the 5 key trends in AI that will define agriculture in 2025. During a panel discussion, he outlined how 2025 will mark the first year AI truly revolutionizes agriculture from lab to field: shorturl.at/CMGtE




The 2025 class of Brevant seeds U.S. brand corn and soybeans from Corteva Agriscience features 39 new products that have been strategically selected to better support farmer needs: shorturl.at/Aopbs



.BASF AgSolutions US is expanding its FiberMax® and Stoneville® cotton seed portfolio with the addition of 6 new varieties for the 2025 growing season. With these new additions, the FiberMax and Stoneville cotton seed portfolio features a total of 13 varieties shorturl.at/l4LnR




Ag groups, including American Seed (ASTA), congratulate Brooke Rollins on her confirmation as USDA Secretary: shorturl.at/LDAhp


Gates Agricultural Innovations (Gates Ag One) and Corteva Agriscience announced a new collaboration to accelerate agricultural innovations in support of global food security: tinyurl.com/khrx72zb







According to ASTA (American Seed (ASTA)) Chair Dan Foor in the First Quarter issue of Seed Today, open communication is a key for leaders to guide their organizations. Plus, Foor sees an opportunity to advocate for the issues that most matter to our sector: shorturl.at/86nKn


.Beck's Hybrids acquires Gro Alliance's corn seed production location in Howe, IN and its soybean seed production location in Mt Pulaski, IL. In addition, Beck’s has assumed Gro Alliance’s lease on 80,000 square feet of warehouse space in Sturgis, MI: shorturl.at/TDG2H